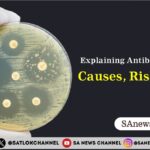
Explaining Antibiotic Resistance Causes, Risks & Fixes

The devastating flood situation in Gudhan village, Tehsil Kalanaur, District Rohtak, had pushed residents into despair for months. With nearly the entire agricultural belt submerged, livestock suffering, and homes severely damaged, neither government departments nor political leaders could provide meaningful help. Endless rounds to offices yielded only false promises and paperwork.
In this moment of complete hopelessness, the villagers turned to Sant Rampal Ji Maharaj, whose Annapurna Muhim has been providing humanitarian relief across more than 300 flood-affected villages in Haryana. The villagers approached Him with their heartfelt plea, and under His divine grace, immediate action was taken. What the system failed to do in months, He ensured in just days. His relief team, working strictly under His divine guidance, delivered life-saving equipment entirely free of cost—without any recommendation, paperwork, or bureaucracy.
Existing Condition of the Village
For three to four months, Gudhan village remained submerged in floodwater. More than 1300–1400 acres of farmland were under 3–4 feet of stagnant water.
- Kharif crops were completely ruined.
- Rabi sowing seemed impossible.
- Livestock struggled for fodder and were on the verge of collapse.
- Houses suffered severe structural damage with large cracks appearing everywhere.
Government pumps were insufficient—only one or two motors were running, barely removing any water. With every passing day, despair grew, and survival became more difficult.
Villagers’ Heartfelt Plea to Sant Rampal Ji Maharaj

When all avenues failed, Gudhan Panchayat prepared a formal request on their official letterhead. They humbly prayed to Sant Rampal Ji Maharaj, requesting:
- 10,000 feet of 8-inch pipeline, and
- Five 15 HP motors
The application carried the signatures of the Sarpanch and all Panch members. Filled with faith and devotion, villagers said that only He could save them now, calling Him ‘the only true divine power on Earth.’
Also Read: Flood devastation in Mundal Khurd and the Immediate help of Sant Rampal Ji Maharaj
Once the prayer reached Him, action was immediate. Villagers testified that while politicians only gave excuses, Sant Rampal Ji Maharaj responded like a divine guardian Who protects His children.
Materials Given Under Sant Rampal Ji Maharaj’s Grace (Under Annapurna Muhim)
Under the sacred Annapurna Muhim, and by the boundless mercy of Sant Rampal Ji Maharaj, within a period of 4-5 days after submitting their request letter, Gudhan village received:
- 10,000 feet of 8-inch pipeline (45 kilia worth)
- Five 15 HP motors
- All necessary electrical starters, fittings, bolts, etc
Even the truck charges, installation assistance, and required accessories were provided under His divine guidance. Villagers repeatedly said that they did not need to buy even a single nail. Everything was arranged seamlessly and quickly—a miracle they had never witnessed before.

A Vision Beyond Temporary Relief
Sant Rampal Ji Maharaj communicated a clear vision for long-term self-sufficiency to the Gudhan Village Gram Panchayat. In His letter, He stressed the necessity of being accountable and utilising the relief materials efficiently to ensure a lasting recovery.
Crucially, He made it a condition that failure to promptly drain the water and sow the next harvest would disqualify the village from receiving future support from the Trust. This directive was intended to cultivate discipline and collaboration, encouraging villagers to treat the assistance as a tool for permanent improvement, not merely a temporary fix.
To maintain integrity, Sant Rampal Ji Maharaj mandated drone footage be taken before and after the relief operations and after the full growth of crops as well. This transparency measure, part of the Annapurna Muhim, guarantees donors and followers can verify that their donations are utilised ethically and effectively. The representative of the Sarpanch accepted these terms, providing assurance that the crops would be replanted without delay.
Villagers’ Voice and Statements
The gratitude and emotion expressed by the people of Gudhan are beyond measure. The grateful villagers unanimously declared that Sant Rampal Ji Maharaj acted like God, or like a father serving His children. They felt ‘blessed’ by His actions, especially since He supplied all materials, including 10,000 feet of pipe and five motors, eliminating their need to purchase anything. They consider Him a present-day God (Bhagwan) and their ‘अन्नदाता’ (Provider of Food), stating His aid saved farmers who would have otherwise been ruined.
Villagers even offered a ceremonial turban (pagdi) to honour Sant Rampal Ji Maharaj, symbolising their complete respect and surrender. They said this gesture represented giving their very head and dedication to Him. Many openly declared that generations to come will remember His grace in this dark time.
A Tribute to the Divine Power of Sant Rampal Ji Maharaj
The experience in Gudhan Village serves as a powerful testament to the limitless spiritual authority held by a Tatvdarshi Sant over all forms of adversity. Through the actions taken under the Annapurna Muhim, Sant Rampal Ji Maharaj demonstrated that the word ‘impossible’ has no place in the dominion of Supreme God Kabir. For the Supreme Being, nourishing and sustaining the entire world is an act of effortless compassion. The flood relief operation executed in Gudhan is concrete proof that under Sant Rampal Ji Maharaj’s divine power, all suffering is acknowledged and every sincere plea is answered.